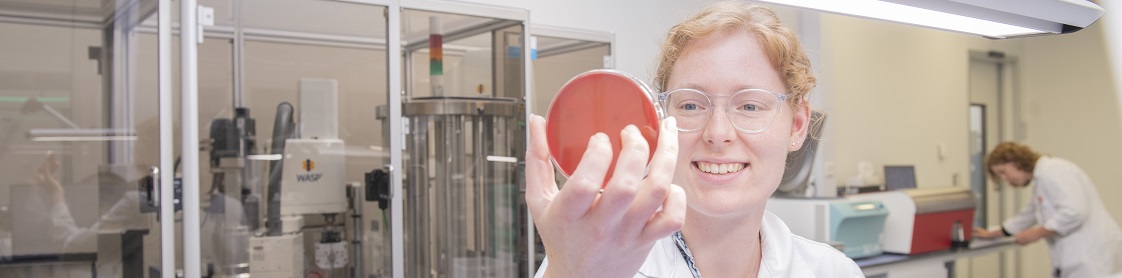

Royal GD is een onafhankelijk en marktgericht bedrijf; onze medewerkers zetten zich met passie in voor diergezondheid. Alles wat we doen richt zich er uiteindelijk op om diergezondheid te verbeteren en te borgen. Volgens medewerkers is de inhoud van hun functie interessant en is er voldoende vrijheid om in een prettige werksfeer zelfstandig invulling te geven aan het eigen werk. Ook is er veel ruimte om werk en privé te combineren. Bij GD hechten we veel waarde aan de persoonlijke en professionele groei van onze medewerkers. Ben je resultaatgericht, slagvaardig en in staat om samen met anderen doelen te realiseren, dan sluit je goed aan bij de cultuur en ambitie van onze organisatie.
Lijkt het jou wat om bij GD aan de slag te gaan? Bekijk dan onze openstaande vacatures. Staat er geen passende vacature bij? Stuur dan een open sollicitatie. Heb je vragen over werken bij GD, kijk dan eens op de pagina met veelgestelde vragen of neem contact op per mail.
Onze vacatures
Expertisen en afdelingen
GD is een onafhankelijk en marktgericht bedrijf met expertise in diergezondheid. We zijn actief in de volgende afdelingen:

De afdeling Research en Development (R&D) ontwikkelt nieuwe producten en verbetert bestaande producten voor de diersector. Daarnaast ondersteunt het team de diersectoren bij acquisitie en uitvoering van extern gefinancierd onderzoek, monitoring, het oplossen van problemen in de dienstverlening en het beantwoorden van vragen over producten en diensten.
Lees verder

In ons moderne laboratorium in Deventer voeren we met circa honderd medewerkers jaarlijks ongeveer vijf miljoen analyses uit voor onze klanten. Naast onderzoek naar ziektes bij dieren, doen we ook grootschalig onderzoek om inzicht te verkrijgen in de diergezondheidssituatie in Nederland. Grootschalige diagnostiek staat centraal in het laboratorium.
Lees verder

GD werkt met circa negentig dierenartsen, specialisten en wetenschappers aan diergezondheid. Ze doen dit door diergezondheidsprogramma's op te zetten, testen te ontwikkelen, kennis te delen en producten te ontwikkelen over diergezondheid, veterinaire diagnostiek, laboratoriumonderzoek en data op internationaal niveau.
Lees verder

Onze stafafdelingen zorgen voor de juiste randvoorwaarden, zodat onze inhoudelijk specialisten in het laboratorium en in de diersectoren zich volledig kunnen richten op het verbeteren van de diergezondheid.
Lees verder

Stage en afstuderen
Tijdens een (afstudeer)stage leer je hoe je jouw geleerde theorie in praktijk brengt; hiermee doe je relevante werkervaring op. Je ziet hoe het er op de werkvloer aan toegaat en je kunt het vakgebied eens in de praktijk ervaren.
Als kennisorganisatie hebben we geregeld interessante afstudeeropdrachten of stages. Bij GD geloven we in de kracht van delen. Kennisdeling brengt inzichten en ervaringen uit verschillende situaties samen, waardoor bij beide partijen nieuwe kennis ontstaat. Heb je interesse in een stage- of afstudeerplek bij GD?
Lijkt het jou wat om bij GD aan de slag te gaan? Wil je meer weten over onze arbeidsvoorwaarden? Staat er geen passende vacature bij? Heb je nog een specifieke vraag? Bekijk dan onze veelgestelde vragen of reageer via een open sollicitatie. Je kunt ook contact met ons opnemen per mail.